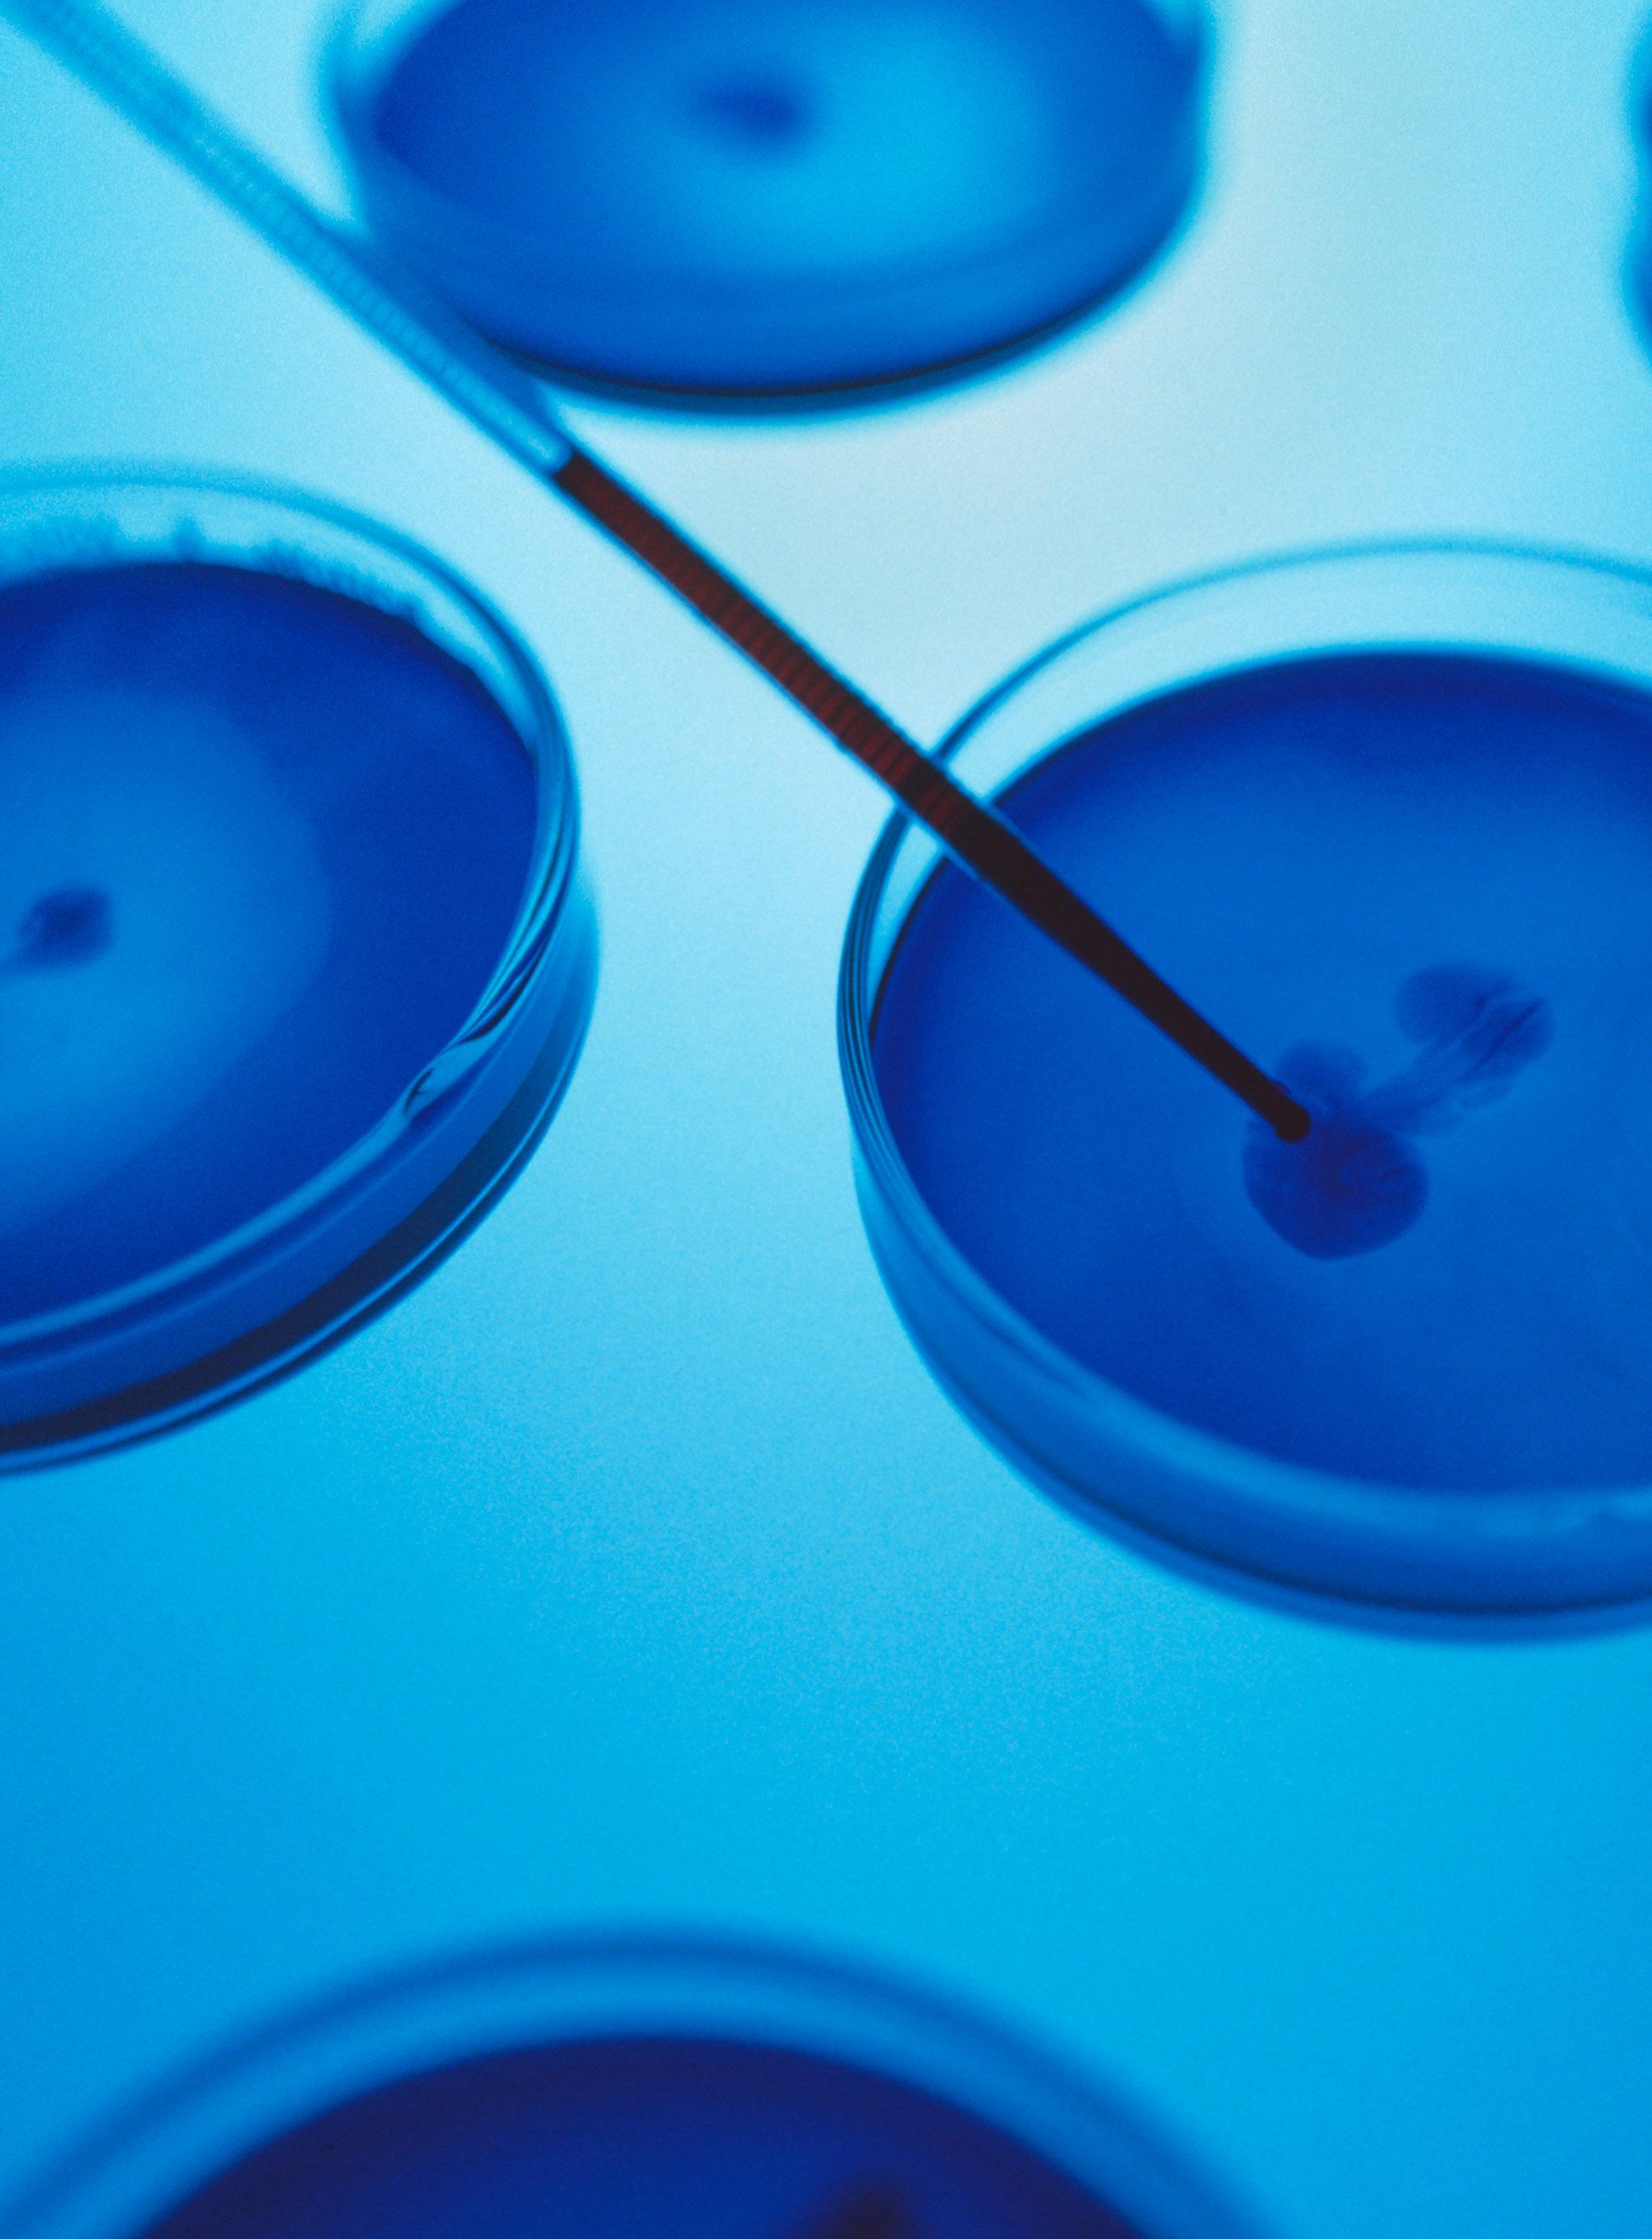

Houston Methodist Academic Institute CORES AT A GLANCE




Fostering innovations for clinical application is at the heart of what we do.
Integrated into one of America’s Best Hospitals. The Houston Methodist Academic Institute is committed to translating laboratory discoveries into novel treatments and cures for our patients, which requires a specialized research and development infrastructure and facilities, coupled with regulatory knowledge and technical expertise—science in service of medicine.
Houston Methodist supports translational research with onsite capabilities for Federal Drug Administration-approved current good manufacturing practice and good laboratory practice studies and early phase (I and II) clinical trials.
Our commitment to the full translational cycle from discovery to cure is how we deliver on our mission of leading medicine.



Houston Methodist Academic Institute
RESEARCH CORES
To support the unique technological needs inherent to conducting translational research, the Houston Methodist Academic Institute has built core facilities that provide investigators and external researchers access to exceptional scientific technology. Whether an investigator is in the initial phase of discovery or is developing, testing or validating a new drug or device, the Academic Institute has a core facility to assist at every step with technical expertise and state-of-the-art equipment.
The translational research cores facilitate moving preclinical discoveries into the clinical phase of development, including the FDA-compliant cGLP facilities that perform safety and risk assessments in preclinical models. The cGMP are facilities designed to produce clinical grade radiopharmaceuticals, nanoparticles or biologicals for preclinical and clinical studies.
The Houston Methodist Academic Institute also provides platform technologies comprised of instruments, techniques and services foundational to basic laboratory research, as well as clinical trial support services offering the infrastructure investigators need for the design, initiation, management and reporting of clinical trials.

Cores & Services Biorepository Core ....................................................................................................... 4 Comparative Medicine ................................................................................................. 5 Microscopy Core (AFM) and X-ray Irradiators ....................................................... 6 Advanced Cellular and Tissue Microscopy Core .................................................. 7 Machine Shop Core 8 Research Pathology Core 9 Flow Cytometry Core 10 Center for Health Data Science and Analytics 11 RNAcore ....................................................................................................................... 12 Translational Imaging Center Magnetic Resonance Imaging (MRI) Core ................................................... 14 Positron Emission Tomography (PET) Imaging Facility .............................. 14 Preclinical Imaging Facility ............................................................................... 15 Cyclotron Core and Nuclear Pharmacy Core .............................................. 16 cGMP Production Support Translational Production and Quality 18 cGMP Core 19 Ann Kimball and John W. Johnson Center for Cellular Therapeutics 20 Center for Rapid Device Translation .............................................................. 22 Clinical Trials Support and Clinical Research Support Academic Office of Clinical Trials ................................................................... 24 Cockrell Center for Advanced Therapeutics Clinical Research Phase I Unit 26

Biorepository Core
The Biorepository Core is a large, general-purpose bank of solid tissue, blood, serum, plasma and other samples for use by Houston Methodist researchers and their collaborators. All sample collection activities are conducted to ensure patient confidentiality, accurate pathologic annotation and high ethical standards before, during and after sample collection.
Services
• Collection, processing and storage in a timely, quality-driven manner of fresh snap-frozen solid tissues from surgical pathology specimens, blood and other body fluids from patients
• Provision of relevant controls including normal solid tissues from same or other patients and/or blood from healthy patients/volunteers
• Centrifugation and aliquoting, PBMC isolation, controlled rate freezing and other specimen preparation methods; ambient, refrigerated, frozen and cryogenic (LN2) storage
• Protocol-specific collection, processing and storage for biospecimens
713.441.4356
Core Director: Rajeev Singh, MBBS, MD, MBA rsingh2@houstonmethodist.org
• Maintenance of a clinical database with basic clinical data elements for all samples in the repository
• Round-the-clock monitoring of freezers with adequate backup and disaster recovery protocols in place
• Current global bio-banking standards followed to ensure research relevance of stored specimens
• Electronic biorepository sample inventory management
• Electronic query tool for biorepository inventory access
• Biorepository Sample Inventory weblnk: samplesearch.houstonmethodist.org
CORES & SERVICES
houstonmethodist.org/biorepository
4 | Houston Methodist Academic Institute

Comparative Medicine
The Houston Methodist Comparative Medicine program conducts studies in both large and small preclinical models offering:
• 65,000 square feet of dedicated state-of-the-art facilities
• Housing space for a variety of preclinical models, individual ventilated caging for rodents and flexible housing configurations for larger preclinical models
• Rodent space managed as a strict barrier, specialized space for imaging and an ABSL2 isolation suite
• Two fully equipped operating rooms and an ABSL3 suite for infectious agents
The program also offers good laboratory practice (GLP)-certified facilities and services for conducting risk, safety and efficacy assessment studies in compliance with current FDA guidelines.
GLP Services
• Write IACUC protocols
• Consultation for GLP protocols
• Assistance for device-related procedures
• Perform preclinical model procedures including injections, blood draws, catheter placements, clinical observations, equipment calibrations, monitoring and necropsy
Core Director: Tanya Herzog, DVM,
houstonmethodist.org/comparativemedicine 713.363.9622
DACLAM thburkholder@houstonmethodist.org
Cores At A Glance | 5

Microscopy Core (AFM) and X-ray Irradiators
The Microscopy Core (AFM) and X-ray Irradiators is a service and research resource equipped to perform scanning electron microscopy, transmission electron microscopy, fluorescent microscopy and atomic force microscopy. The staff will train and assist with imaging samples. This Core is a fee-for-use and fee-for-service facility that is open to the Texas Medical Center community.
Services
Electron Microscope and Sample Preparation
The facility provides essential equipment for sample preparation, including a sputter coater for applying a thin layer of conductive material, a Critical Point Dryer to prevent cell wall damage during drying, and the Ultramicrotome Leica EM UC7 for easy preparation of semi- and ultra-thin sections for various microscopy examinations.
Training Sessions
To ensure proficiency in operating the scanning electron microscope, training sessions are required. This includes an introductory session and hands-on training with a standard sample.
• Bruker MultiMode Atomic Force Microscope Equipment
• Bruker Biocatalyst Atomic Force Microscope
• FEI Nova NanoSEM 230
• X-Ray Irradiators—the RS-2000 and the SmART+ system
Core Director: Gu (James) Jianhua, PhD
CORES & SERVICES
houstonmethodist.org/electron-microscopy 713.441.9955
jgu@houstonmethodist.org
6 | Houston Methodist Academic Institute

Advanced Cellular and Tissue Microscopy Core
The Advanced Cellular and Tissue Microscopy Core provides assistance with experimental design, specimen preparation, advanced microscope imaging techniques and complex imaging processing software for quantitative data analysis of cell biology and tissue pathology samples. The Core specializes in various forms of wide-field imaging, high-resolution laser scanning confocal microscopy, live-cell imaging systems and high-content screening systems.
Equipment
• Fluoview FV3000 Confocal Microscope
• Nikon NSPARC Confocal Microscope
• IncuCyte® S3 Live-Cell Imaging System
• ImageXpress Micro High Content Screening Widefield Microscope
• ImageStreamX High Resolution Microscopy in Flow
• Spero® Infrared Chemical Imaging Microscope
• Total Internal Reflection Fluorescence Microscope
• EVOS™ FL Auto Imaging System
• Two-photon intravital microscope
• NEW Olympus VS200 digital slide scanner
• NEW NanoString GeoMX DSP, nCounter, CosMX imager
• NEW Optical coherence tomography (OCT) microscopy
• NEW Coherent anti-stokes Raman scattering (CARS) microscopy
• 10X Genomic Visium spatial transcriptomics imaging
• Various high power 2D/3D/4D microscopy imaging processing and visualization software packages
Core Director: Stephen T. Wong, PhD
Core Staff: Matthew Vasquez
Core Manager: Hong Zhao, MD, PhD
Cores At A Glance | 7 houstonmethodist.org/tissue-cellular-imaging 713.441.3557
msvasquez@houstonmethodist.org
hzhao@houstonmethodist.org

Machine Shop Core
The Machine Shop Core develops prototypes of medical devices and other instruments by providing concept creation, product design and precision machining services. A broad range of materials are available for device fabrication, including polymer, carbon-steel, stainless steel, brass, copper, titanium, polycarbonate, peek and delrin. Prototype devices developed in the Machine Shop include the DeBakey rotary blood pump, preclinical model holder, Nedo pump and infant tongue depressor.
• Design consultation
• Developing prototypes for medical devices
• Fabricating custom laboratory equipment
Equipment Services
• 13” Colchester Lathe
• LeadWell V-30iF CNC Mill
• Precision Hardinge Toolroom Lathe
• Knee Mills
• CNC Benchman Mill
houstonmethodist.org/machineshop 713.441.6399
Core Director: Juan A. Fernandez jafernandez@houstonmethodist.org
• Implement improvements to device designs
• Device repair
• Vertical and Horizontal Saws
• Shear and Brake Metal Fabricator
• Table Saw
• Silver Soldering Capabilities
CORES & SERVICES
8 | Houston Methodist Academic Institute

Research Pathology Core
The Research Pathology Core assists with routine histology techniques such as embedding tissue, sectioning tissue blocks and staining sections. Custom tissue blocks prepared by the core staff include multi-tissue arrays. Immunohistochemistry services provide antibody characterization and optimization, and immunohistochemical and immunofluorescence staining. This Core also handles both preclinical tissue samples and patient samples with required approvals.
Services
• Specimen processing and embedding
• Microtomy
• Design and creation of tissue microarrays
• Cryostat training and technical support
• Tissue staining (H&E, Gram, GMS, Iron, Von Kossa)
• Immunohistochemistry (antibodies provided by core or investigator)
• Titration/optimization of antibodies
• Immunofluorescence (antibodies provided by investigator)
• Consultation with a pathologist, upon request
• Provide supplies (e.g. cassettes, formalin, slides, molds and slide boxes)
• Rush Service Available (additional fee)
houstonmethodist.org/researchpathology
713.441.2662
Core Director: Andreana Rivera, MD alrivera@houstonmethodist.org
Cores At A Glance | 9

Flow Cytometry Core
The Flow Cytometry Core provides training, instrumentation, technical expertise and software for flow cytometric analysis and cell sorting. The Core uses fluorescent probes, usually labeled antibodies, to identify cells. Information about the relative size and granularity of a cell is recorded and the result is a visual presentation describing an individual or group of cellular events. If needed, the cells or particles can be separated by sorting and further analyzed.
Equipment
These instruments allow scientists to make very concise measurements at the cellular level, evaluate a large number of samples in a short time frame and gather information on very rare populations of cells.
NIR BD FACS AriaII - A six-laser instrument with 355, 405, 488, 550, 635 and 785 nm excitation sources, capable of 18-color analysis. This instrument is equipped with a Forward Scatter PMT in addition to the FSC photodiode. This instrument is capable of high speed sorting, sample depending. Temperature controlled sample and collection chambers with four-way and single-cell deposition are available.
SORP BD FACS AriaII - A four-laser instrument with 405, 488, 550 and 635 nm excitation sources capable of 13-color detection. This instrument is also capable of high speed sorting, sample depending. Temperature-controlled sample and collection chambers with four-way and single-cell deposition are available.
BD Symphony A5SE - Five lasers with 349, 405, 488, 561 and 637 nm excitation, spectral 48-color channels available.
BD FACS Fortessa - A four-laser instrument with 405, 488, 561 and 630 nm excitation sources, capable of 13 color analysis, and equipped with a Forward Scatter PMT in addition to the FSC photodiode.
A Millipore Guava 8-HT - A two-laser instrument with 488 and 635 nm excitation sources capable of six color detection. The 8-HT provides rapid 96-well handling capability for screening assays.
Sony MA900 Sorter - Four laser, 405, 488, 561, 635 nm excitation, capable of sorting into plates and tubes.
houstonmethodist.org/flowcytometry 713.441.9233
Core Director: David L. Haviland, PhD, CCy dlhaviland@houstonmethodist.org
CORES & SERVICES 10 | Houston Methodist Academic Institute

Health Data Science & Analytics
The Center for Health Data Science and Analytics includes data scientists, data analysts and statisticians who work with clinicians and researchers to assist faculty, staff and trainees explore, manage, collate and analyze research and clinical data from multiple sources.
Research Study Design & Support
• Workflow optimization, innovative tracking, predictive and advanced analytics, outcomes measures, and cost reduction for quality improvement and population health management
• Statistical power and sample size determination
Research Data Pipeline Services
• Clinical study data collection and management through REDCap
• Algorithm development and numerical methods
• Cohort determination
• Linear and non-linear programming
• Statistical and advanced data modeling
• Inferential hypothesis testing
• Support for developing recommendations, grants, manuscripts and presentations for a variety of audiences and stakeholders
• Study design and data analyses for clinical and laboratory experiments
• Experimental data management and exploration
• Data mining from curated electronic medical records and curated databases
• Machine learning and artificial intelligence applications to biomedical data
Core Director: Stephen L. Jones, MD, MSHI
Co-Director: Khurram Nasir, MD, MPH
Core Research Administrator: Jennifer Taylor, MBA
HDSA@houstonmethodist.org 346.356.1469 Cores At A Glance | 11
RNACore
The RNAcore is a leader in RNA synthesis, supported by the Cancer Prevention and Research Institute of Texas. The RNAcore is staffed by experienced scientists who provide services for the development, generation, and encapsulation of high-fidelity mRNA, and support fundamental research and clinical applications. With the use of efficient, fast construct generation, we can provide a wide range of generic or personalized RNA molecules for any desired species, with various modifications.




The RNAcore produces high fidelity research and clinical grade RNA, including:
• mRNA
• Modified mRNA (mmRNA)
• Self-amplifying mRNA (saRNA)
• Long noncoding RNA
• Customized bicistronic constructs
• Constructs with reporter genes
RNA molecules can be produced for any species, for any loci of interest and synthesized as modified mRNAs, incorporating any of the following:
• Modified nucleotides
• 5’ Caps (ARCA, CleanCap, M6)
• Long 150 nt poly-A tail
• Sequence optimization Services
RNA molecules can also be generated as:
• Research-grade, with or without HPLC purification
• cGMP-grade
RNA Lipid-encapsulation Services
Analytical Services
• Nucleic acid integrity by Bioanalyzer/TAPE station
• Integrity and purity assessment by HPLC
• Impurity assessment of Residual template DNA by qPCR
• Impurity assessment of Residual E. Coli DNA by qPCR
• Endotoxin testing with the Nexgen-MCS
• Analysis of size, charge and encapsulation efficiency of lipid nanoparticles
CORES & SERVICES
12 | Houston Methodist Academic Institute
An example of the superiority of mRNA vaccines made by the RNAcore at Houston Methodist and those made in an external academic lab as assessed by the immune response of vaccinated animals. Attention to sequence, structure, base modifications, purification, encapsulation, and other factors can improve translational efficiency and efficacy of RNA products.
Core Director: John P. Cooke, MD, PhD
Research Project Manager Business Development: Elisa Morales, MS
houstonmethodist.org/rnacore 713.441.7283 RNAcore@houstonmethodist.org
Cores At A Glance | 13
10 1 10 2 10 3 10 4 10 5 10 6 10 7 Neutralizing Antib ody T iters * ** Unvaccinated Empty
Ps
NA
LN
mR
Commercial Kit (Academic Lab)
mR NA CleanCap (HMH)
* ** Unvaccinated Empty LN Ps mR NA Commercial Kit (Academic Lab) mR NA CleanCap (HMH) mR NA AR CA (HMH) RNA IDEA Small Biotech · Academic Group HMH Center · RNA Therapeutics ENCAPSULATE cGMP PRODUCTION GLP PRECLINICAL STUDIES PHASE I (FIRST IN MAN) DESIGN · SYNTHESIZE · PURIFY · LYOPHILIZE · VALIDATE HMH · Nanomedicine HMH · cGMP 1 2 3 4 5 HMH CMP 6 HMH · Cockrell Unit PHASE II · PHASE III FDA APPROVAL 8 VGXI MARKET 7 RNA DRUG DEVELOPMENT RNA DRUG TRIALS MARKET RNA IDEA Roadmap to Clinic
mR NA AR CA (HMH)
Translational Imaging Center
The Translational Imaging Center provides clinicians and researchers with access to the most advanced, high-performance imaging equipment to create a direct translational environment for innovation. The Center supports preclinical and clinical investigative studies and provides magnetic resonance imaging (MRI), positron emission tomography (PET) with an onsite cyclotron and a preclinical imaging clinic to perform multimodality imaging studies on preclinical study models.



Magnetic Resonance Imaging (MRI) Facility
• Human MRI scanners equipped to perform a variety of research studies: first clinical 7 Tesla MRI (Siemens MAGNETOM Terra) and a state-of-the-art 70 cm wide-bore 3 Tesla whole-body MRI scanner (Siemens MAGNETOM Vida) in proximity to the positron emission tomography (PET) facility to facilitate high-throughput multi-modality imaging
• Clinical and preclinical imaging (9.4 T Bruker vertical bone MRI scanner) services to help design experiments, acquire complex images and perform clinical translational research studies
Positron Emission Tomography (PET) Imaging Facility
• Provides a variety of highly customizable advanced imaging services including the production of cGMP-grade radiopharmaceuticals and research-dedicated PET scanning of patients and large preclinical models using a state-of-the-art research-dedicated Siemens Vision PET/CT
• Fully equipped to perform kinetic modeling studies with arterial input function and correction for radiometabolites
CORES & SERVICES 14 | Houston Methodist Academic Institute
Preclinical Imaging Facility
The Preclinical Imaging Facility offers researchers access to cutting-edge imaging technologies, services, and expertise necessary for conducting multi-modality imaging studies on small animal models with human diseases.
Areas of Expertise
• Positron emission tomography (PET), singleproton emission computed tomography (SPECT), computed tomography (CT), magnetic resonance imaging/magnetic resonance spectroscopy (MRI/MRS), optical imaging, and MRI-guided high-intensity focused ultrasound (HIFU) treatments.

• Full technical support in instrumental operation and data acquisition, comprehensive training, assistance with experimental design and imaging data analysis. The facility also provides custom radiolabeling services in investigational drugs, antibodies, peptides and other small molecules.


Preclinical Imaging Equipment
• 7 Tesla MR scanner for mice and rats with MR Solutions’ Dry Magnet technology
• PET INSERT for simultaneous PET/7T-MR imaging or co-registered PET/CT scan
• Benchtop CT scanner from MR Solutions
• SPECT scanner for SPECT/CT, SPECT/MR, SPECT/PET imaging
• MR-guided focused ultrasound system for HIFU treatment
• IVIS Spectrum and Spectrum CT for bioluminescence, fluorescence imaging, and CT scan
• Wizard2 Automatic Gamma Counter for tissue biodistribution measurement
MRI Director: Christof Karmonik, PhD ckarmonik@houstonmethodist.org houstonmethodist.org/mri-core 713.441.7979
MRI Medical Director: Steve H. Fung, MD shfung@houstonmethodist.org
PET Director: Moonsoo Jin, PhD mjin@houstonmethodist.org houstonmethodist.org/pet-facility 713.441.7979
Preclinical Imaging Director: Zhonglin Liu, MD zliu2@houstonmethodist.org houstonmethodist.org/preclinicalimaging 346.238.4189
Cores At A Glance | 15
Translational Imaging Center
Cyclotron Core and Nuclear Pharmacy Core
Cyclotron Core
The Cyclotron Core was started to address the unmet needs of bringing investigational radiopharmaceuticals within patient reach. Few academic institutions have a cGMP-compliant cyclotron facility committed to manufacturing research radiopharmaceuticals, which attracts investigators and industry sponsors aiming to provide clinical translation of promising radiopharmaceuticals, particularly in preclinical to early phase clinical trials. The Cyclotron Core collaborates with both the Nuclear Pharmacy and PET Imaging Core to provide unmatched translation of novel radiotracers into clinical practice. Additionally, this Core supports the Preclinical Imaging Core with radioisotopes and radiotracers.
Services
• Contract manufacturing for both in-house and industry sponsored research radiopharmaceuticals
• Radiopharmaceutical manufacturing process validation
• Perform radiodistribution and radiometabolite testing to determine the degree metabolites will interfere with a diagnostic scan
Equipment
• General Electric (GE) PETtrace 16.5 MeV negative ion isochronous cyclotron
• Nine ventilated hot cells for housing radiosynthesis modules
• Six radiosynthesis modules for production of C11, F18, Ga68, and NH3
• Fully equipped quality control laboratory with four Agilent HPLC’s, two Scion GC’s, two TLC scanners, and an MCA
• Provide preclinical evaluation of radiopharmaceutical toxicity studies
• File regulatory applications for submission to the FDA such as Investigational New Drug (INDs) and Abbreviated New Drug (ANDAs) applications
• Internal quality control testing for radiopharmaceuticals (i.e. radiochemical and radionuclidic tests, pyrogen and sterility tests)
• Two ISO 5 dispensing hot cells with telemanipulators for radiopharmaceutical patient specific dose dispensing.
• ISO 5 clean room for aseptic assembly of sterile components in manufacturing
16 | Houston Methodist Academic Institute
CORES & SERVICES

Nuclear Pharmacy Core
As one of the nation’s few academic research nuclear pharmacies with access to an onsite cyclotron, the Nuclear Pharmacy Core collaborates with physicians and researchers from various specialties such as oncology, cardiology, urology, and neurology to safely compound, prepare and dispense sterile radiopharmaceuticals for patient-specific diagnostic imaging scan or therapeutic treatment. This Core coordinates with the cyclotron for radiopharmaceutical manufacturing and the Positron Emission Tomography (PET) Imaging Core for in-house diagnostic imaging providing translation of novel radiotracers into clinical practice.
Services
• Authorize Nuclear Pharmacists and Technicians will compound, prepare, and dispense FDA approved clinical and investigational radiopharmaceuticals
• Review clinical trial drug study protocols for site initiation
• Assess drug safety (pharmacovigilance) profile
• Advise on facility design for implementation of radiotherapeutic drugs
Equipment
• USP 825 and State Board of Pharmacy compliant nuclear pharmacy facility with aseptic ISO 5 dispensing hot cell and telemanipulators for radiopharmaceutical dispensing
• Provide expertise on United States Pharmacopeia (USP) 825 compliance of radiopharmaceuticals
• Establish environmental monitoring program for maintaining sterile processes
• Perform acceptable quality control set forth by USP Monographs or Manufacturer’s specifications
• Distribute internal and external radiopharmaceuticals
• USP 797 compliant dedicated ISO 5 clean room for nonradioactive aseptic preparations and manufacturing processes
Cyclotron Core & Nuclear Pharmacy Core Directors: Meixiang (Max) Yu, PhD myu@houstonmethodist.org houstonmethodist.org/cyclotron 713.441.8220
Richard Le, PharmD, BCNP, MCTM rle@houstonmethodist.org 713.441.5256
Cores At A Glance | 17
cGMP Production Support
Translational Production and Quality
The Office of Translational Production and Quality provides a robust Quality System through its cGMP Core and GMP facilities—the Houston Methodist Drug and Device Core and the Ann Kimball and John W. Johnson Center for Cellular Therapeutics—that can support the planning, execution and management of translational projects involving the manufacturing and testing of molecular, nanotech, and cellular therapies within the Houston Methodist Academic Institute.




Houston Methodist has two GMP facilities and an onsite cGMP Quality Core offering investigators unparalleled opportunities for generating novel clinical grade therapeutics.
CORES & SERVICES
18 | Houston Methodist Academic Institute
cGMP Core
The cGMP Core onsite quality control laboratories provide testing and release for manufactured products with strict adherence to FDA requirements. These tests confirm the quality, identity, purity and strength of the manufactured drugs in order to ensure that we deliver a safe and effective product to our patients.
Services
• Endotoxin Testing
• Environmental Monitoring
• ICH Stability Storage and Testing
• Inorganic Impurities Testing
• Method Development and Validation
Equipment
• Accumet pH Meter
• Agilent 2100 Bioanlyzer
• Beckman Coulter Multisizer 4e
• BioRad CFX Connect
• Charles River PTS Endotoxin System
• Denovix Spectrophotometer
• Fisher Scientific Conductivity Meter
• Karl Fischer Titrator
• Malvern Viscotek GPCmax
• Malvern Zetasizer Nano ZS
• Organic Volatile Impurity Testing
• QC (batch release) and Raw Materials Testing
• Temperature Mapping
• Water Analysis
Core Director: Daniel J. Kota, PhD djkota@houstonmethodist.org
• Mettler Toledo Excellence XS Microbalance
• Mettler Toledo NewClassic MS Analytical Balance
• Mettler Toledo Portable TOC
• Mettler Toledo TGA Star
• Shimadzu GC2010 Plus
• Shimadzu ICP-MS 2030
• Shimadzu IRAffinity
• Shimadzu Prominence HPLC (ELSD)
• Shimadzu UV1800
• Thermo Scientific Muffle Furnace
houstonmethodist.org/translational-production-quality 713.208.0639
Cores At A Glance | 19
Ann Kimball and John W. Johnson Center for Cellular Therapeutics
The Ann Kimball and John W. Johnson Center for Cellular Therapeutics (KJCCT), or the Johnson’s Center, is a 5,000-square-foot facility that includes 1,710 square feet of cleanroom space, a dedicated quality control laboratory, support spaces, and material, equipment and cryogenic storage required for GMP operations. Six independent production rooms, furnished with state-of-the-art equipment allow investigators and expert personnel to translate laboratory discoveries into cutting-edge cellular therapies for patient care. cGMP Production Support

CORES & SERVICES 20 | Houston Methodist Academic Institute
Services
• Cell Processing/Manufacturing and Cryopreservation
• Method Development and Validation
• Cryostorage
• Cell Characterization
• Sterility Testing
• Endotoxin Testing
• Mycoplasma Testing
• Autoclave Sterilization
• QC (batch release) and Raw Materials Testing
• Regulatory Consultation
Cell Processing/Manufacturing and Cryopreservation Equipment
• Sepax C-Pro Cell Processing System
• CliniMACs Plus Cell Depletion and Enrichment System
• CliniMACs Prodigy Automated Cell Processing System
• VIA Thaw CB1000
• Cook Regentec CellSeal Automated Thawing DFS
• TSCD-II Sterile Tubing Welders
Equipment
• BioMerieux BACT/ALERT 3D
• Countess™ II FL Automated Cell Counter
• CliniMACs Quant Flow Cytometer
• Endosafe® nexgen-PTS™
• Synergy HTX Multi-mode Reader
• Lucetta 2 Luminometer
• Carl Zeiss™ Primo Vert™ Inverted Microscopes
• SEBRA 2380 Tube Sealer Kits
• NUAire 6 ft. Biological Safety Cabinets
• CO2 Incubators
• ME1002TE Precision Balances
• VIA Freeze
• Cryomed Controlled Rate Freezer
• CryoPlus™ LN2 Vapor Freezers houstonmethodist.org/kjcct
713.208.0639
Core Director: Daniel J. Kota, PhD djkota@houstonmethodist.org
• Previ Color Gram
• BIOFIRE® Mycoplasma Nucleic Acid Amplification Technique (NAT)
• CFX Opus 96 Touch Real-Time PCR Detection System
• Mettler Toledo™ Excellence Plus XPE Analytical Balance
Cores At A Glance | 21
cGMP Production Support
Center for Rapid Device Translation
The Center for Rapid Device Translation (CRDT) guides clients through preclinical studies and regulatory approval pathways to bring new medical devices to market. CRDT provides full-service expertise and study execution to achieve preclinical device validation—opening the door for early-phase clinical testing when required by a regulatory agency.
As industry innovators, our clients have access to entrepreneurs and scientists with invaluable expertise and insight during the foundational planning and first phases of product development and testing. CRDT connects clients to core services that move innovative medical devices and biologic therapies from bench to bedside with safety, accuracy and efficiency. Key industry leaders include JLABS @ TMC, Siemens Healthineers and Automobili Lamborghini. The Center helps clients move a medical device toward commercialization by:
• connecting clinical experts for project input
• creating prototypes of medical devices
• conducting preclinical studies
• preparing for early-phase clinical trials

CORES & SERVICES
22 | Houston Methodist Academic Institute
Preclinical Testing & Validation
• Navigate effective regulatory pathways through preclinical device testing
• Prepare technologies, tools and facilities for applying Good Laboratory Practice (GLP)
• Conduct successful safety studies
• Achieve robust data for regulatory agency approval
Houston Methodist Drug & Device Facility
The Houston Methodist Drug & Device Facility is a state-of-the-art cGMP-compliant manufacturing facility for producing therapeutics and devices for first-in-human clinical trials. These therapeutics and devices are produced under tightly controlled regulations, which is critical for the translation of novel discoveries from bench to clinic. The facility houses four isolated, independent production rooms which provide versatility in the manufacturing of a variety of therapeutic drugs (mRNA, nanomaterials and nanoparticles) and devices. Additionally, the facility houses a dedicated room for aseptic fill/finish and packaging prior to transfer of manufactured drugs and devices for release testing, pre-clinical and clinical use.


rapiddevicetranslation.org 713.363.9931
Program Director: Homer Quintana, MCTM hquintana@houstonmethodist.org
Cores At A Glance | 23
Clinical Trials Support
Academic Office of Clinical Trials
The Academic Office of Clinical Trials (AOCT) provides investigators with experienced and certified research coordinators, regulatory personnel and a financial infrastructure to support internally and externally sponsored clinical research. Serving as a liaison between investigators and industry sponsors, the AOCT facilitates integration of clinical research operations throughout Houston Methodist and is responsible for the Clinical Trials Management System.

The Academic Office of Clinical Trials staff offers resources to new and experienced investigators to conduct innovative clinical research.
CORES & SERVICES
24 | Houston Methodist Academic Institute



Resources
Regulatory Support
• IRB Submissions and Amendments
• Informed Consent Preparation
• Regulatory Document Preparation and Management
Research Coordinator Support
• Study Feasibility and Initiation
• Investigator Meetings
• Subject Screening, Enrollment and Follow-up
• Specimen Collection
Financial Support
• Cost Assessment
• Study Budget Preparation and Negotiation
• Invoicing
• Investigational New Device (IND) and Investigational Device Exemption (IDE) Applications
• IP Accountability
• Data Collection
• Case Record Form (CRF) Completion
• CTMS Entry
• Study Closeout
• Financial Reporting
• Reconciliation of Study Cost Center
houstonmethodist.org/clinical-research-services
713.441.3250
Academic Office of Clinical Trials
Director: Pauline Todd, MBA, BSN, RN ptodd@houstonmethodist.org
Manager: Lenis Sosa, MSN, BSN, RN, OCN lsosa@houstonmethodist.org
Cores At A Glance | 25
Clinical Research Support
Clinical research support at Houston Methodist enables rapid translation of potential treatments or technologies from the preclinical stage into early phase clinical trials. The Cockrell Centers for Advanced Therapeutics offer six sites throughout greater Houston and a Phase 1 Unit in the heart of the Texas Medical Center for clinical research support. These Centers provide a full range of outpatient clinical care and study management services, including regulatory submissions and budget management support for all phases of clinical trials.
Cockrell Centers for Advanced Therapeutics
The Cockrell Centers for Advanced Therapeutics promote and support clinical research operations with more than 7,000 square feet of clinical research space and are staffed by research nurses, coordinators and regulatory personnel to support internally and externally sponsored clinical research. The Centers are available to support clinical trials closer to the homes and workplaces of study participants.
• Exam rooms for outpatient studies
• Private rooms for infusion services
• Semiprivate rooms for infusion services and/or serial blood sampling
• Fully equipped specimen processing laboratory
• Adjacent state-of-the-art inpatient services including critical care monitoring
• Secure storage, preparation and dispensing services for investigational products with 24/7 temperature monitoring
CORES & SERVICES
26 | Houston Methodist Academic Institute
Resources
Cockrell Center for Advanced Therapeutics
Clinical Research Phase 1 Unit
The Phase 1 Unit, located in Houston Methodist Hospital’s Main Six Southeast wing, is involved with early-phase and proof-of-concept clinical trials and conducting advanced pharmacokinetic or pharmacodynamic evaluations. The Unit is conveniently located adjacent to inpatient units for inpatient studies and to a radiology facility that is dedicated to clinical trials. The Phase 1 Unit also serves as the storefront for health professionals seeking assistance with translational medical research associated with state-of-the-art precision medicine.
Services
• Early-phase Clinical Trials
• Research Outpatient Services
• Regulatory and Budget Management
• Pharmacokinetic and Pharmacodynamic Sampling (extended hours)
• Infusion Services (investigational drugs, biologics, cell products)
COCKRELL CENTERS FOR ADVANCED THERAPEUTICS
- TMC
houstonmethodist.org/ccat 713.441.1240
Cockrell Centers for Advanced Therapeutics
Director: Pauline Todd, MBA, BSN, RN ptodd@houstonmethodist.org
Cockrell Centers for Advanced Therapeutics
Clinical Research Phase 1 Unit
Director: Maen A. Abdelrahim, MD, PhD, PharmB mabdelrahim@houstonmethodist.org
Cores At A Glance | 33 HOUSTON METHODIST RESEARCH INSTITUTE
CLINICAL
HOUSTON METHODIST
SUGAR LAND HOUSTON METHODIST SUGAR LAND HOSPITAL WEST HOUSTON HOUSTON METHODIST WEST HOSPITAL PEARLAND HOUSTON METHODIST PRIMARY CARE GROUP THE WOODLANDS HOUSTON METHODIST THE WOODLANDS HOSPITAL 1 2 3 4 5 6 5 4 3 2 1 146 6
RESEARCH PHASE 1 UNIT
HOSPITAL
Cores At A Glance | 27
ABOUT HOUSTON METHODIST
HOUSTON METHODIST
U.S. News & World Report named Houston Methodist to its prestigious Honor Roll—the best hospitals in the country. Our flagship hospital is the No. 1 in Texas for the 12th year in a row*.
Houston Methodist is affiliated with two of the nation’s leading health care organizations, Weill Cornell Medicine and NewYork-Presbyterian Hospital. With 3,270 operating beds, 197 operating rooms and more than 32,100 employees, Houston Methodist offers unparalleled care for thousands of patients from around the world.
*Tied with UT Southwestern, Dallas, 2023-2024
HOUSTON METHODIST ACADEMIC INSTITUTE
The Houston Methodist Academic Institute oversees the Education Institute and Research Institute, including 815 faculty and 67,000 learners. The Academic Institute aligns our research and education initiatives in service to the clinical mission, providing solutions that answer the call for new technologies and skills our clinicians need for patient care.
The Houston Methodist Education Institute coordinates our primary academic affiliation with Weill Cornell Medicine and other joint programs, including the Engineering Medicine Program at Texas A&M University School of Engineering Medicine. The Education Institute also oversees continuing medical education and graduate medical education, and supports more than 1,260 students and postgraduate trainees for medical, nursing, allied health and research education programs.
The Houston Methodist Research Institute supports research programs and infrastructure that enable faculty across the system to bring new scientific discoveries to patients as rapidly as possible through the full cycle of a cure from conceptual bench research, to prototyping and development, to clinical trials and FDA approval. The Research Institute supports more than 1,690 clinical studies and trials and $90 million in extramurally funded translational research programs.
7 4,500+ 101,508 2,043 43 814,309 268 1,000+ 440,000 20,000 8 Hospitals 5,070 Physicians 815

71 GME Programs
Patient
388 GME Residents and Fellows 1,690 Clinical Studies and Trials 660,000
ft. Dedicated Research Space 32,100
Houston Methodist System Fast Facts As of January 2024
Faculty
2.23M
Encounters
Sq.
Employees







Houston Methodist Academic Institute 6670 Bertner Street Houston, TX 77030 houstonmethodist.org/research HMRI Office of Communications & External Relations | SET | DH | 05.2024